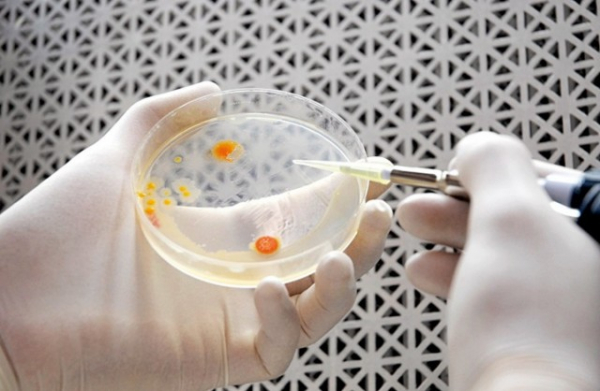
Создан самый эффективный в мире метод выпуска биотоплива

Команда исследователей из Вустерского политехнического института (WPI, Массачусетс) открыл инновационный метод производства биотоплива, который является самым экономически эффективным и экологически чистым из всех существующих.
В журнале Nature Communications исследователи WPI опубликовали статью под названием «Инженерное производство и утилизация микробного биотоплива в условиях сверхкритического диоксида углерода». В ней ученые подробно описывают особенности своего открытия и его потенциал для экологически чистого и дешевого производства изобутанола.
Разработчики из WPI говорят, что их новый метод позволяет производить биотопливо с затратами энергии в пять раз меньшими, чем традиционные способы производства. В их процессе используется сверхкритическая двуокись углерода в качестве растворителя вместе с бактерией, генетически модифицированной, чтобы быть в состоянии противостоять суровой окружающей среде, создаваемой этой антимикробной жидкостью.
Данная прорывная бактерия является устойчивым к сверхкритическому CO2 штаммом Bacillus megaterium. Внедрение этой бактерии позволило команде WPI обойти ловушки бактериального загрязнения и низкой выработки – два основных препятствия, которые традиционно затрудняют производство биотоплива.
Новый процесс, разработанный командой WPI, может быть использован для дешевого производства изобутанола. Полученный изобутанол может затем использоваться в качестве добавки к традиционному бензину или даже как самостоятельное топливо, сообщает ресурс Oil Price.
Изобутанол – это спирт, похожий на этанол, обычную добавку к бензину на биологической основе, но он имеет более низкую растворимость в воде и большую энергоемкость. Это означает, что он более экономичен и менее агрессивен, чем этанол. Отличный биотопливный потенциал изобутанола не новость, но он всегда был слишком дорогим, чтобы производить его в значительных масштабах – до сих пор.
«Мы сделали расчеты, чтобы доказать, что эта методика работает и работает хорошо, – сказал доцент кафедры химического машиностроения WPI Майкл Тимко канадскому журналу Biomass Magazine. – У нас были предположения, что это будет работать, но вопрос был в том, будет ли данная методика энергоэффективной. Оказывается, это так».
Нет Ответов